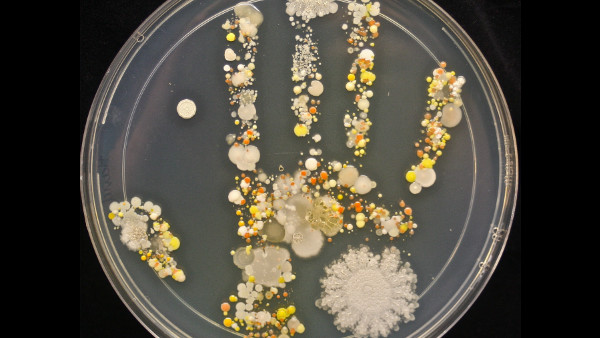
Handprint Petri Dish Germs Bacteria

10 Things We Learned From Infectious Disease Expert Michael Osterholm On Joe Rogan Experience
1. Coronavirus: What's Being Done To Get A Vaccine In Place?
Remarkably, Osterholm admitted that a vaccination could be made overnight. It's whether the vaccine would be safe or suitable for mass production and distribution that needs to be taken into consideration.
Tests, therefore, need to be done on each potential vaccine. To check the vaccine is safe and working, the usual process is to put it into animals, before giving it to a few humans. All volunteers, of course - even though Rogan suggested convicted criminals.
Gradually these tests would work up to larger studies over time in order to find out what the risk factor is in terms of the vaccine being ineffective or causing bad/fatal side effects. These studies are happening as fast as they can and Osterholm gave the example of if a farmer wanted to farm his land in half the time, he couldn't do so by doubling the amount of land he plants his seeds in.
Osterholm summarised that it could be years before we get a successful vaccine for this Coronavirus, but that it's important we stick at it and keep trying to find a cure. We can't make the same mistakes we have in the past of forgetting about the virus as soon as it appears to go away.
There may be other valuable things we missed in this deeply engaging episode of The Joe Rogan Experience so be sure to check it out for yourself in order to get better educated on the subject of the Coronavirus and other infections that exist today.